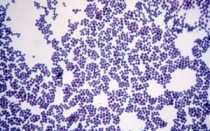
Кокки в мазке

Свежие публикации
Одестон при камнях в желчном можно ли применять Одестон – лекарственное средство, которое входит в группу препаратов для терапии патологий...
Прыщи на ляжках — причины, у мужчин и женщин, между ног, как убрать, появились, фото Прыщи на ляжках появляются у...
Когда можно пить алкоголь после приема антибиотиков Антибиотики и алкоголь несовместимы – это известно каждому. Но насколько верно это утверждение?...
Почему болит под пальцами на ноге? На протяжении дня ноги испытывают значительную нагрузку. Боль под пальцами на ноге может возникнуть...
Консультация генетика при беременности Наследственность играет немаловажную роль в жизни каждого человека. Благодаря ей мы берём от наших родителей черты...
Часто люди, пришедшие в аптеку, задаются вопросом: «Какое средство для лечения гайморита или ринита выбрать: спрей «Изофра» или «Полидекса»? Кажется,...
Как должна выглядеть нормальная реакция Манту Туберкулёз входит в список наиболее опасных заболеваний. Ежедневно бацилла Коха поражает около 30 человек...
Коагулазонегативные стафилококки: что это, особенности и лечение В природе существуют микроорганизмы, способные вырабатывать токсины, нарушающие жизнедеятельность клеток живого организма, разрушительно...
Как выглядит язык при гастрите — оценка состояния Все человеческие органы тесно взаимосвязаны друг с другом. Изменения, касающиеся внутренних процессов...
Показать ещё